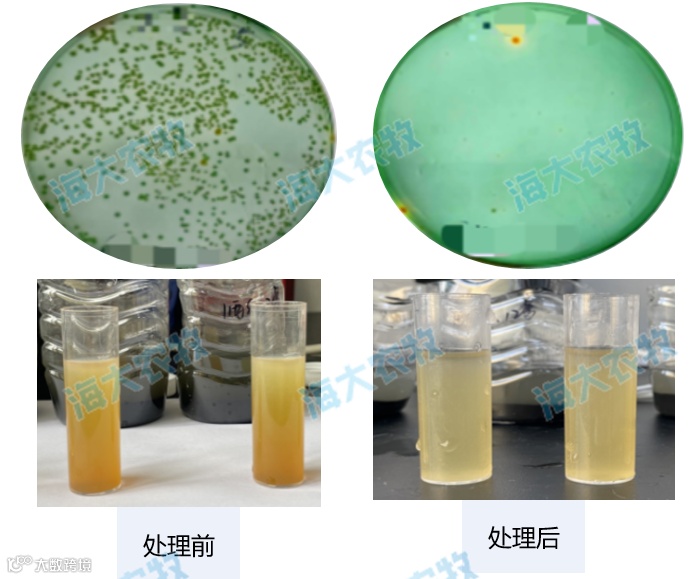

文 | 浙江海大 翟富德
导语:山东小棚仍有部分养殖户能取得高产、高效益!
受极端天气影响,2024年山东小棚受到前所未有的灾难性打击,但是在这种情况下仍有部分养殖户能取得高产、高效益!以下为部分我司合作客户出虾案例:

出虾情况
东营新户镇新渤园区林老板,12月21日出虾,投喂浙江海大饲料虾多康,累计投喂3888斤,出虾3205斤,规格27头,料比1.21,单棚利润超万元,虾子体色靓、价格高、拉虾成活率高!
一、科学规划,争赶价格高峰
养殖规划
冬棚养殖从8月中旬-次年4月下旬,养殖周期8个月。
第一季:8月中旬投苗到12月中旬出虾,养殖周期110-120天,放苗密度7-8万尾/棚,以高产、大虾模式为主;
第二季:12月下旬投苗到次年4月中旬出虾,养殖周期90-100天,放苗密度6-6.5万尾/棚,以快、大虾模式为主。

近三年虾子价格走势
根据近三年虾价走势分析:清明节前后为全年虾价格最高时间节点,五一节后价格出现回落;总的分析虾价受虾子规格影响,大规格虾子价格优势更明显,市场供需稳定。

③盈利模型分析
通过盈利模型进行分析,产量2000斤/棚,单斤虾成本14元;按照往年同期虾价进行分析,虾价19元/每斤单棚盈利1万元左右,虾价20元/斤单棚盈利超万元,虾价25元/斤单棚盈利2万元以上。

二、养殖关键点
好苗配好料
1
1)苗种-成功的根本
好的苗种是成功的根本,近两年检测发现苗种问题频发!客户更倾向于选择大厂家苗种,对比我司合作园区海兴农苗种近两年占比情况,海兴农苗种比例持续升高,苗种长速快、表现稳定!

1
2)饲料虾多康+硬壳宝
根据今年虾子价格对比精品虾与常规虾出虾情况,精品虾价格普遍17元以上,普通虾价格15元左右,单棚产量1800斤,单棚利润差3600元,单组棚利润相差14万元。

养殖中期虾多康:保肝、抗病、活力好!添加抗病因子及护肝因子,全面提高对虾对外界刺激的抵抗力以及肝脏的修复能力!
养殖后期硬壳宝:强营养、提体色、促硬壳!提高虾子品质!

硬件配套
增氧机配比:单组40张棚,单棚增氧机功率达到2kw以上;养殖过程中及时调整增氧机功率,确保水体溶氧充足。
增氧盘配比:2个/米,长短交叉四排排列确保曝气均匀。
单棚增氧机功率:养殖前期不低于1kw/棚,养殖中后期大于1.5kw/棚。

养殖管理
1
Ⅰ、投喂管理
全程3餐投喂,加料平稳,累计投喂量3800斤/棚左右;
养殖前期控料时间60分钟,确保虾子摄食量,提高虾子体质;
养殖中后期控料时间70分钟以内,避免过度投喂导致水质恶化、虾子负担重等情况发生。

1
Ⅱ、弧菌管理
养殖过程中弧菌处理采用外消+内服+改底三位一体操作,同步处理水体、虾体、塘底弧菌,弧菌含量保持在安全范围值以内。
消杀:扫浑期后7-10天/次(根据弧菌超标情况);
改底:养殖前期5-7天/次,养殖中后期2-3天/次;
内服:清弧肽拌料1餐/天。
1
Ⅲ、亚盐管理
1)高菌高碳模式:通过大量补充有益菌与碳源保证有益菌存活率及生态占位、激活池塘原有土著菌。
补菌:泡菌20斤/次,2-3天/次;复合芽孢1斤/次+光合菌原液3-5斤/次,2-3天/次;两种补菌方式交替使用。
补碳:碳源2-3斤/次,2次/周。
2)低换水模式:全程使用低换水模式确保水环境稳定性,调水为主促进菌藻平衡,避免水质剧烈波动引起虾子应激、有益菌成活率低等情况发生。
放苗后5天不套水
扫浑期前套水1小时/天
养殖中后期套水3-4小时/天
3)底质管理:通过检测底泥弧菌、氨氮超标严重,建议养殖中后期定期改底,2天/次,改底产品与石灰颗粒交替使用,定期使用碱化塘底、提升水体pH值。
单餐投喂量低于10斤/餐,1.5斤/次/棚,2次/周;
单餐投喂量高于10斤/餐,2斤/次/棚,2天/次。
1
Ⅳ、钾离子平衡
水质检测结果显示养殖区域整体钾离子含量偏低,而钾离子含量不足会导致虾子生长缓慢、免疫力下降、蜕壳困难、成活率降低等一系列问题发生,整个养殖周期内定期补钾使钾离子含量维持在150mg/L以上;
投苗前:钾离子含量120mg/L以上;
投苗后:钾离子含量维持在150mg/L以上;
补充:3-5斤/次,2次/周。
(根据区域水质条件实际情况进行调整)

三、小结
行情低迷无法改变,但是通过优化养殖规划与过程管理提高养殖成功率,同样可以取得一份满意答卷!“满堂红”才是盈利根本!浙江海大服务团队始终坚持初心,深耕本土化养殖技术总结,围绕着互利双赢的理念服务客户,致力于提高养殖成功率,同客户携手同行、共度难关!
有养殖技术相关疑问,欢迎扫码留言咨询

本文系海大农牧(微信号:haid002311)原创,未经授权,一律禁止转载!文章投稿、转载授权,欢迎发邮件到:haidnm@haid.com.cn

👇 咨询产品可点击"阅读原文"留言

